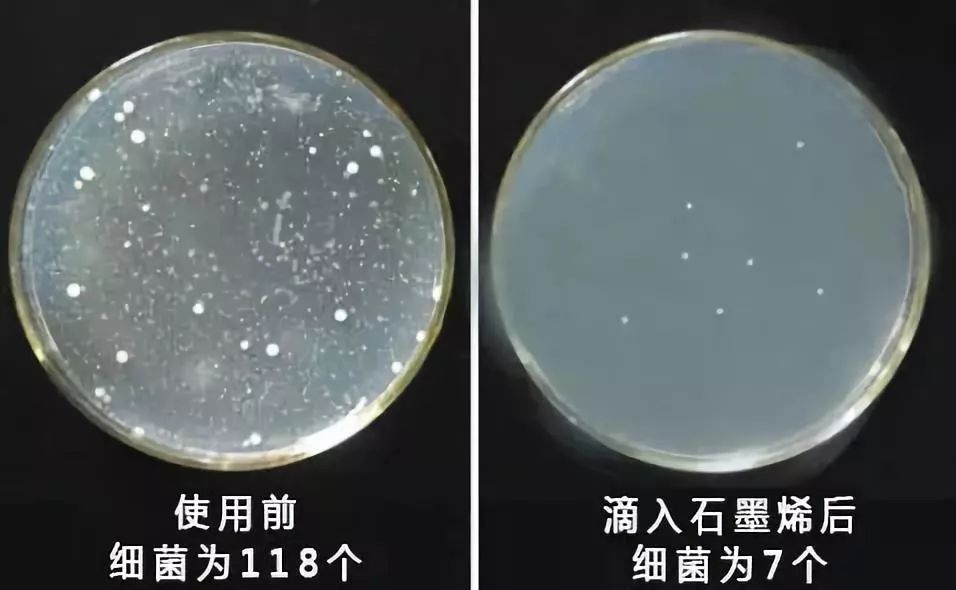
女生不注意下身卫生的危害,不注意个人卫生的表现女生

女人这生了孩子呀,就容易惹上宫寒。畏寒又怕冷,不仅手脚冰凉、腰酸背痛,更可怕的是来一次姨妈,都疼的卧床不起。

还有一件事反反复复惹人心烦的就是妇科疾病了。妇科门诊去了一次又一次,却始终没能根治,折磨着身心健康。

其实女性80%的妇科疾病和宫寒都与*裤内**有关。咱们经常穿的*裤内**,不管是棉质的,还是竹纤维*裤内**,裆部都容易发黄,发皱。

这些发黄的裆部上有着无数的阴道细菌,它们会侵入你体内,造成反复感染。每多穿一次,就多给它一次感染你的机会。
所以想要远离这些麻烦的问题,第一步就是选条好*裤内**。今天馆长给大家带来这款石墨烯3D磁疗暖宫*裤内**。

它采用石墨烯裆部,让细菌无法滋生。同时利用艾草磁疗暖宫技术驱赶湿寒,让子宫暖暖的,越穿越健康。
购买通道

双层石墨烯护裆,杀菌去异味
裆部采用双层石墨烯,它具有强大的杀菌抑菌功能,能将*处私**残留的细菌杀灭。

当石墨烯的裆部滴上水后,面料会迅速吸水,瞬间变成蜂窝状结构。此时释放出的大量石墨烯能量,开始杀菌抑菌,让裤裆时刻保持干净,消除妇科隐患。

尤其是在女性生理期,病菌最为猖狂的时候,裆部的石墨烯成份能将经期滋生的99%细菌、真菌统统杀死。
同时裆部的面料也是选用的顶级莫代尔,更加柔软舒适,能减少裆部与*处私**摩擦带来的不适与伤害。

艾草磁疗,驱寒暖宫
采用国外黑科技针织技术,将艾草和磁点融入进面料中,形成暖宫驱寒的养护层。

磁点与磁点之间会不断产生远红外热能,穿着时腹部会不断升温,确保子宫始终暖暖的,维持在一定的温度,保护着腹部,拒绝外界寒气入侵。

磁点中还镶嵌着艾草精华,在远红外升温的同时,艾草挥发出其驱寒散阴的特性。每天它穿上24小时,相当于艾灸2小时。
在艾草源源不断的阳气助攻下,子宫深处的寒气会不断被排出,从而达到温经驱寒的效果。

除了能发热暖腹,*裤内**上的磁点还能疏通腰部带脉,加快新陈代谢能力,活血更新细胞。带脉一旦通畅,女性妇科问题就会得到缓解。

购买通道

3D臀杯,收腹翘臀
更棒的是,这款*裤内**的臀部还采用了3D立体臀杯设计。大扇形的蜜桃臀设计有力的将臀部向上托起,朝中间聚拢,长期穿戴,能塑造美好臀型。

穿上之后原本下榻的臀部赘肉瞬间被聚拢,臀部变得圆润有曲线。

高腰设计,并加宽了腰带,收腹有力,小肚腩瞬间被藏起来了。超舒适,不勒腰~

舒适贴身,无骨缝制
这款*裤内**的面料十分讲究。采用活氧面膜纱,被称为内衣界的奢侈品,它集细、轻、柔、薄、贴为一体。

贴在身上就像人的第二层肌肤,有种被包裹感,却没有任何厚重感。

另外,采用机械无骨缝合技术,比手工缝纫更加精密、贴合。

*裤内**采用100%天然植物染色技术,上色更均匀、颜色更牢固。即使用100℃的开水浸泡半小时,也不会有丝毫的掉色。

超强弹力,不限体型。不管你是80斤的骨感美女,还是150斤的胖女神,都可以轻松驾驭它。

购买过的用户,都是好评如潮!

4种颜色任你选,建议多买几条替换穿!

大商场专卖店需要100元以上,但是今天粉丝特惠,限时优惠只需39.9元。千万不要错过哦~
购买通道
